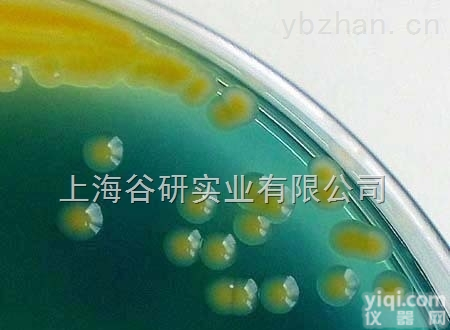
珊瑚色诺<em>卡氏</em>菌操作<em>步骤</em>

未知诺卡氏菌操作步骤
- 品牌:DSMZ
- 产地:进口/国产
- 供应商:上海一研生物科技有限公司
- 供应商报价:面议
- 标签:未知诺卡氏菌操作步骤,1,上海一研生物科技有限公司
资源名称 未知诺卡氏菌操作步骤
种属 Nocardia ignorata
分离基物 土壤
提供形式 斜面培养物
安全等级1
模式菌株 no
培养方法 培养基 39
生长条件 20℃
存储条件 液氮超低温冻结法;矿物油法;定期移植法
详细说明
描述 菌落较小,乳白色,颗粒状,反面咖啡色;基内菌丝断裂,孢子丝螺旋或弯曲
我公司专业代理ATCC菌种,未知诺卡氏菌操作步骤价格优惠,质量保证,为大中型科研提供严格质量体系控制的ATCC,CMCC,CICC,DSMZ标准菌株。欢迎广大科研用户!
产品名称 | |
种属 | Nocardia ignorata |
发货地 | 上海 |
保藏方法
1. 传代培养保藏法
又有斜面培养、穿刺培养、疱肉培养基培养等(后者作保藏厌氧细菌用),培养后于4-6℃冰箱内保存。
2. 液体石蜡覆盖保藏法
是传代培养的变相方法,能够适当延长保藏时间,它是在斜面培养物和穿刺培养物上面覆盖灭菌的液体石蜡,一方面可防止因培养基水分蒸发而引起菌种死亡,另一方面可阻止氧气进入,以减弱代谢作用。
3. 载体保藏法
是将微生物吸附在适当的载体,如土壤、沙子、硅胶、滤纸上,而后进行干燥的保藏法,例如沙土保藏法和滤纸保藏法应用相当广泛。
4. 寄主保藏法
用于目前尚不能在人工培养基上生长的微生物,如病毒、立克次氏体、螺旋体等,它们必须在生活的动物、昆虫、鸡胚内感染并传代,此法相当于一般微生物的传代培养保藏法。病毒等微生物亦可用其他方法如液氮保藏法与冷冻干燥保藏法进行保藏。
5. 冷冻保藏法
可分低温冰箱(-20-30℃,-50-80℃)、干冰酒精快速冻结(约-70℃)和液氮(-196℃)等保藏法。
6. 冷冻干燥保藏法先使微生物在极低温度(-70℃左右)下快速冷冻,然后在减压下利用升华现象除去水分(真空干燥)。有些方法如滤纸保藏法、液氮保藏法和冷冻干燥保藏法等均需使用保护剂来制备细胞悬液,以防止因冷冻或水分不断升华对细胞的损害。保护性溶质可通过氢和离子键对水和细胞所产生的亲和力来稳定细胞成分的构型。保护剂有牛乳、血清、糖类、甘油、二甲亚砜等。
概念:
一,菌种的概念 原意是指孢子(相当于植物的种子) ,但在实际生产中,常将经过人工培养的纯菌丝体连同培养基质一同叫做菌种。
二,菌种的类型 在生产中根据菌种的来源,繁殖代数及生产目的,把菌种分为母种,原种和栽培种.分别叫一级种,二级种,三级种。母种:将纯菌丝体或孢子在试管培养基中繁殖而成.可以繁殖原种,也适宜菌种保藏.原种:母种菌丝在固体培养基上繁殖而成.这一过程增强菌丝对培养环境的适应性,又起到扩繁的作用.原种可以直接出菇。
LILRA5 Protein Rat 重组大鼠 LILRA5 蛋白 (Fc 标签)
Anti-HMGA1 (high mobility group AT-hook 1 0.5mgAnti-HMGA1 (high mobility group AT-hook 1) 高迁移率族蛋白A1抗原
EPHB3重组小鼠 EphB3 / HEK2 蛋白 (His 标签) Protein
A2M Protein Human 重组人 A2M / CPAMD5 / Alpha-2-macroglobulin 蛋白 (His 标签)
IFITM3重组人 IFITM3 蛋白 (Fc 标签) Protein
ENTPD5重组小鼠 ENTPD5 蛋白 (His 标签) Protein
肝素酶(HPA)重组蛋白 Recombinant Heparanase (HPA)
SLAMF6重组人 SLAMF6 / Ly108 蛋白 (Fc 标签) Protein
PDE4B Protein Human 重组人 PDE4B / DPDE4 蛋白 (His & GST 标签)
HAVCR1 Protein Cynomolgus 重组食蟹猴 KIM-1 / TIM1 / HACVR1 蛋白 (His 标签)
EPOR Protein Human 重组人 EPOR / Erythropoietin Receptor 蛋白 (Fc 标签)
PTEN/MMAC1(CT 0.5mgPTEN/MMAC1(CT)human, mo, rat, pig, dog, bovine, horse, chicken 一种YZ基因抗原(C端)
HA重组乙型流感 (B/Florida/4/2006) 血凝素HA2 (Hemagglutinin) 蛋白 (Fc 标签) Protein
AACS重组人 AACS / Acetoacetyl-CoA Synthetase 蛋白 (His 标签) Protein
SBDS Protein Human 重组人 SBDS / Shwachman-Bodian-Diamond syndrome 蛋白 (His 标签)
肝素酶(HPA)重组蛋白 Recombinant Heparanase (HPA)
PDE4B Protein Human 重组人 PDE4B / DPDE4 蛋白 (His & GST 标签)
ENTPD5重组小鼠 ENTPD5 蛋白 (His 标签) Protein
HAVCR1 Protein Cynomolgus 重组食蟹猴 KIM-1 / TIM1 / HACVR1 蛋白 (His 标签)
SLAMF6重组人 SLAMF6 / Ly108 蛋白 (Fc 标签) Protein
Anti-Phospho-HDAC4(Ser246)/HDAC5(Ser259)/HDAC7(Ser155)/FITC 荧光素标记磷酸化组蛋白去乙酰化酶4、5、7抗体IgGMulti-class antibodies规格: 0.2ml
Anti-Pdk4/FITC 荧光素标记丙酮酸脱氢酶激酶4抗体IgGMulti-class antibodies规格: 0.2ml
Rhesus antibody Rh BAFF/CD257 TNF家族B细胞激活因子抗体 规格 0.2ml
FRA1/FOSL1 peptide FRA-1多肽蛋白 1mg
galectin 9 英文名称: 半乳糖凝集素9抗体 0.2ml
Rhesus antibody Rh Rabbit Anti-pig IgG/PE-CY5 PE-CY5标记的兔抗猪IgG 规格 0.1ml
Anti-Pdk4/FITC 荧光素标记丙酮酸脱氢酶激酶4抗体IgGMulti-class antibodies规格: 0.2ml
SSTR3 peptide 生长抑素受体3抗原Multi-class antibodies规格: 0.5mg
Anti-phospho-B-Raf (Ser445) 磷酸化B-Raf抗体Multi-class antibodies规格: 0.1ml
Rhesus antibody Rh PEPT2/SLC12 肠道肽转运蛋白2抗体 规格 0.1ml
CD106 浓缩 0.1ml 进口分装
phospho-Tau protein(Ser396) 英文名称: 磷酸化微管相关蛋白抗体 0.1ml
phospho-M-CSF Receptor(Tyr809) 英文名称: 磷酸化巨噬细胞集落刺激因子受体抗体 0.1ml
Anti-phospho-B-Raf (Ser445) 磷酸化B-Raf抗体Multi-class antibodies规格: 0.1ml
Anti-NF-L/FITC 荧光素标记低分子量神经丝蛋白抗体IgGMulti-class antibodies规格: 0.2ml
Anti-VSIG4 /FITC 荧光素标记T淋巴细胞负调节蛋白之一抗体IgGMulti-class antibodies规格: 0.2ml
神经母细胞特异性转移因子抗体 Anti-ASCL1/MASH1 0.1ml
Goat Anti-human IgM/PE-Cy3 PE-Cy3标记的羊抗人IgM 0.1ml
GPR37L1 英文名称: G蛋白偶联受体GPR37样蛋白1抗体 0.2ml
Rhesus antibody Rh PRDX5/PRDX6 过氧化还原酶5/6抗体 规格 0.1ml
Anti-VSIG4 /FITC 荧光素标记T淋巴细胞负调节蛋白之一抗体IgGMulti-class antibodies规格: 0.2ml
Mouse Anti-human IgM/HRP 辣根过氧化物酶标记的小鼠抗人IgM 0.1ml
GAPDHS 英文名称: 3-磷酸甘油醛脱氢酶抗体 0.1ml
糖尿病相关肽/胰岛淀粉样肽抗体 Anti-Amylin 0.1ml
Anti-NCX3/FITC 荧光素标记钠钙交换蛋白3抗体IgGMulti-class antibodies规格: 0.2ml
Rhesus antibody Rh PROK2/Prokineticin 2 前动力蛋白2抗体 规格 0.2ml
Anti-VEGF(Rabbit)/FITC 荧光素标记血管内皮生长因子抗体IgGMulti-class antibodies规格: 0.2ml